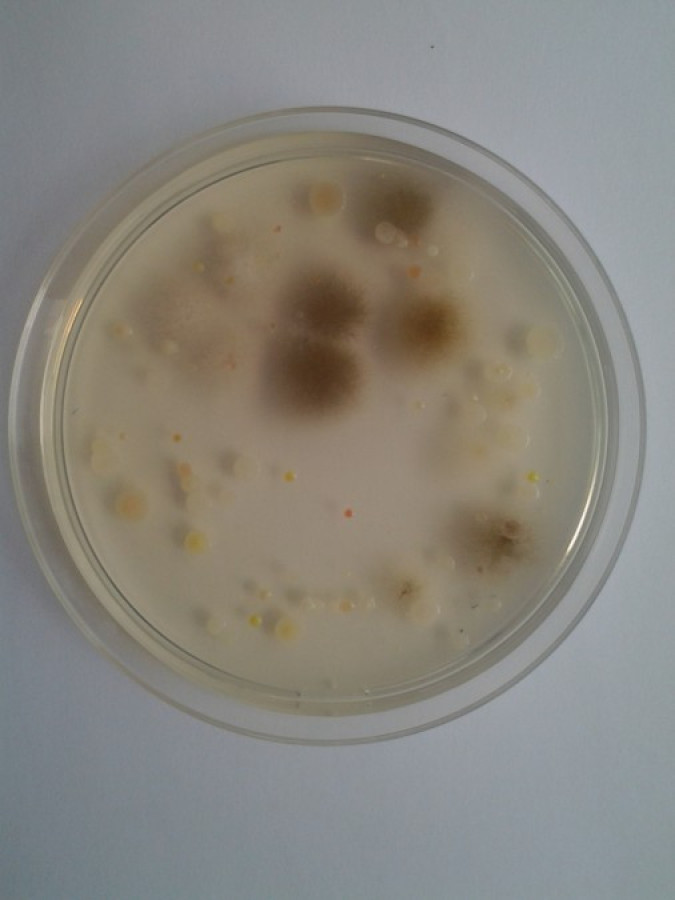
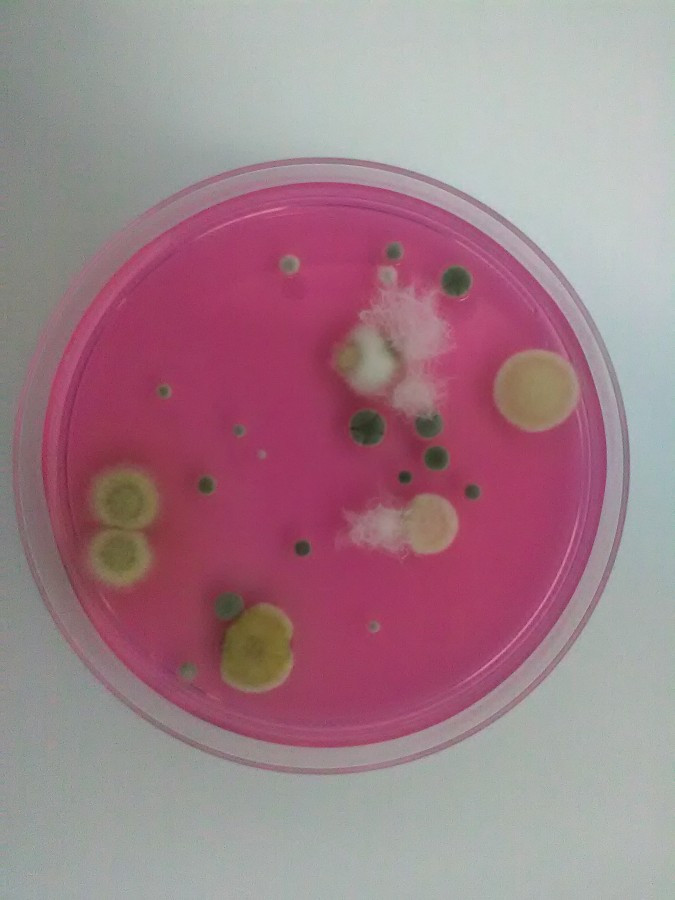

2016-12-15
Gyergyószentmiklós levegőjét is bevizsgálták
Hat székelyföldi város levegőjének mikrobiológiai vizsgálata
Október végén – november elején Csíkszereda, Székelyudvarhely, Gyergyószentmiklós, Tusnádfürdő, Sepsiszentgyörgy és Kézdivásárhely városi levegőjének mikrobiológia vizsgálata alapján megállapítható, hogy a legtöbb mikroorganizmus (baktériumok és penészgombák) Csíkszereda levegőjében, míg a legkevesebb Tusnádfürdőn volt kimutatható.
A Sapientia Erdélyi Magyar Tudományegyetem környezetmérnök szakának Go Green programjához kötődően október végén – november első felében hat székelyföldi város levegőjének minőségét tanulmányozták mikrobiológiai szempontból. A vizsgálatokat a csíkszeredai Kós Károly Szakközépiskola két diákja, Salamon Tímea és Sánta Emese végezték, Székely Bernadett tanárnőjük, és Kuzman Ildikó Hajnalka doktorandusz hallgató segítségével. A kutatásokat Dr. Máthé István mikrobiológus, a Biomérnöki Tanszék környezetmérnök szakának oktatója vezette.
Levegő-mintavétel
A vizsgálatok során korszerű levegő-mintavételi készülék és a mikroorganizmusok szaporítására használt ún. táptalajok segítségével meghatároztuk, hogy az adott mintavételi helyen mennyi volt a baktériumok illetve a penészgombák összcsíraszáma egy köbméter (1000 liter) levegőre számítva. Mindenik városban a mintavétel napsütéses, 5-8 Celsius fok léghőmérsékletű, jelentősebb szélmozgásoktól mentes hétköznapon történt, 14-16 óra között. Városonként 7-8 mintavételi pontot jelöltünk ki, igyekezve arra, hogy forgalmas útkereszteződéseknél, vasútállomáson, piacokon, parkokban is történjen mintavétel.
Vizsgálatok helyszínei
A hat városban a vizsgált helyszínek az alábbiak voltak:
Csíkszereda: Hargita megyei törvényszék melletti körforgalom, Vasúti felüljáró előtti körforgalom (Penny Marketnél), Kaufland Áruház környéke, Márton Áron Főgimnázium melletti útkereszteződés, Központi Piac, Vasútállomás, Központi park, Főtér.
Székelyudvarhely: Református Kollégium előtti útkereszteződés, Buszállomás, Kaufland Áruház környéke, Központi Piac, Vasútállomás, Szoborpark, Központi park.
Gyergyószentmiklós: Salamon Ernő Elméleti Liceum előtti főút, BRD Bankhoz közeli nagy körforgalom, Buszállomás, Kaufland Áruház környéke, Zöldséges üzletsor (Kossuth Lajos utca), Vasútállomás, Központi park, Központi Játszótér.
Tusnádfürdő: CEC Bankhoz közeli útkereszteződés, Tusnád Hotel előtti főút környéke, Petrom töltőállomás melletti piac környéke, Csukás Hotel felé vezető út mentén, Csukás-tó partja, Tusványos tábor bejárata, Vasútállomás, Központi játszótér.
Sepsiszentgyörgy: Rompetrol benzinkúthoz közeli nagy körforgalom, Buszállomás környéke, Kaufland Áruház környéke, Központi Piac, Vasútállomás, Központi Park, Gödri Ferenc Általános Iskola előtti út.
Kézdivásárhely: Boldog Özséb Templom előtti körforgalom, Nagy Mózes Elméleti Gimnázium előtti főút, Gábor Áron Művelődési Oktatási Központ melletti út, Kaufland Áruház környéke, Központi Piac, Vasútállomás, Molnár Józsiás Park.
A székelyföldi vizsgálat eredményei
A 45 mintavételi ponthoz kötődő 90 mikrobiológiai vizsgálat összesített eredményei alapján megállapítható (a részletes adatokat lásd a Mellékletben), hogy a vizsgált időszakban a tanulmányozott hat székelyföldi város közül Csíkszereda levegőjében volt a legmagasabb a mikrorganizmusok (baktériumok + penészgombák) összesített átlagos csíraszáma (2417 mikroba/m3 levegő, amelyből 1642 penész/m3 és 775 baktérium/m3).
Csíkszereda után Székelyudvarhely városi levegőjében a legmagasabb a mikroorganizmusok átlagos csíraszáma (1324 mikroba/m3, ebből 1019 baktérium/m3, a többi penész), majd Sepsiszentgyörgy (1119 mikroba/m3, amelyből 865 baktérium/m3), Kézdivásárhely (987 mikroba/m3, ebből 442 baktérium/m3), Gyergyószentmiklós (817 mikroba/m3, amelyből 532 baktérium/m3) következik a sorban, míg Tusnádfürdő város levegője bizonyult a legtisztábbnak mikrobiológiai szempontból (711 mikroba/m3, ebből 423 baktérium/m3).
 Az összes mintavételi pontot tekintve Csíkszeredából került ki a három mikrobiálisan leginkább terhelt helyszín: Márton Áron Főgimnázium melletti útkereszteződés (5133 mikroba/m3 levegő, ebből 4800 penész/m3), a Törvényszék melletti körforgalom (4867 mikroba/m3, amelyből 4587 penész/m3), illetve a vasúti felüljáró előtti nagy körforgalom (3320 mikroba/m3, ebből 2120 baktérium/m3). A fenti helyszíneken kívül kiugróan magasnak mondható a mikrobák száma a székelyudvarhelyi Kaufland Áruház környékén (3013 mikroba/m3, ebből 2853 baktérium/m3), a csíkszeredai központi piacon (2813 mikroba/m3, ebből 1600 baktérium/m3), a kézdivásárhelyi vasútállomásnál (2613 mikroba/m3, ebből 1867 penész/m3), vagy a sepsiszentgyörgyi Rompetrol benzinkúthoz közeli körforgalomnál (1854 mikroba/m3, ebből 1667 penész/m3).
Az összes mintavételi pontot tekintve Csíkszeredából került ki a három mikrobiálisan leginkább terhelt helyszín: Márton Áron Főgimnázium melletti útkereszteződés (5133 mikroba/m3 levegő, ebből 4800 penész/m3), a Törvényszék melletti körforgalom (4867 mikroba/m3, amelyből 4587 penész/m3), illetve a vasúti felüljáró előtti nagy körforgalom (3320 mikroba/m3, ebből 2120 baktérium/m3). A fenti helyszíneken kívül kiugróan magasnak mondható a mikrobák száma a székelyudvarhelyi Kaufland Áruház környékén (3013 mikroba/m3, ebből 2853 baktérium/m3), a csíkszeredai központi piacon (2813 mikroba/m3, ebből 1600 baktérium/m3), a kézdivásárhelyi vasútállomásnál (2613 mikroba/m3, ebből 1867 penész/m3), vagy a sepsiszentgyörgyi Rompetrol benzinkúthoz közeli körforgalomnál (1854 mikroba/m3, ebből 1667 penész/m3).
Nemzetközi tudományos vizsgálatokkal alátámasztott az a tény, hogy a levegőben levő mikrobák száma szorosan összefügg a levegőben lebegő szemcsék számával (szállóporok és ülepedő porok), és leggyakrabban ezek felületére tapadnak a levegőben előforduló mikroorganizmusok (baktériumok, penész- és élesztőgombák, vírusok, egysejtű protozoonok). Ezen megállapításhoz kötődően a székelyföldi vizsgálat eredményei alapján is általánosságban elmondható, hogy egy városon belül leggyakrabban az intenzív autósforgalmú nagy útkereszteződéseknél, körforgalmaknál, esetenként vasútállomásoknál (pl. Kézdivásárhely, Gyergyószentmiklós) a legmagasabb a levegőben levő mikroorganizmusok száma, ami összefügg azzal, hogy ilyen helyeken minden bizonnyal a legmagasabb a levegőben levő lebegő szemcsék száma. Még a legtisztább levegőjű Tusnádfürdő központjának főútja mentén is a mikroorganizmusok száma (1453 mikroba/m3 levegő) több mint kétszerese a tusnádi átlagos mikrobaszámnak.
A városi központi piacoknál is gyakran sok mikroba mutatható ki a levegőben (pl. Csíkszereda, Kézdivásárhely, Székelyudvarhely, Sepsiszentgyörgy), amely a nagy vásárló embertömeg, és főként a sok gyümölcs- és zöldség jelenlétével magyarázható, amelyek felületén gyakran elszaporodnak a penészgombák és baktériumok. Egy adott városon belül a mikroorganizmusok legkisebb számban általában a fákkal, zöld övezettel tarkított parkok levegőjéből voltak kimutathatók (pl. gyergyószentmiklósi-, csíkszeredai központi park).
Összehasonlítás más vizsgálatokkal
A kültéri levegő mikrobaszámára vonatkozóan nincsenek törvényben szabályozott maximális határértékek megállapítva, csak az élelmiszeripari egységek belső levegőjének mikrobiális terheltségére vonatkozóan vannak határértékek (maximum 600 baktérium/m3 levegő és legfeljebb 300 penész/m3 levegő). Az Egészségügyi Világszervezet (WHO) egy 1998-as jelentésében legfeljebb 500 penész/m3 levegő értéket tart elfogadhatónak épületek belső levegője esetében.
Annak ellenére, hogy nincsenek határértékek, a székelyföldi városok kültéri levegőjének vizsgálati eredményeit viszonyítani tudjuk hazai és nemzetközi hasonló vizsgálatok adataihoz. Romániában a miénkhez hasonló tanulmányt Temesváron készítettek 2008-ban, hasonló helyszíneken (pl. forgalmas utak, vasútállomás, park, piac stb.) és hasonló időszakban is vizsgálódva.
A két kutatást összevetve elmondható, hogy Temesvár levegőjében átlagban 1,7-szer több mikroorganizmust találtak (4140 mikroba/m3 levegő), mint a legmagasabb értékekkel rendelkező Csíkszereda esetében. Az egyes mikrobacsoportok tekintetében Temesváron a baktériumok átlagos csíraszáma (3550 baktérium/m3) 3,5-ször nagyobb, mint a székelyföldi tanulmány esetében Székelyudvarhelyhez kapcsolódó legmagasabb átlag baktériumszám. Ugyanakkor Temesváron a penészgombák átlagos száma (590 penész/m3) közel háromszor volt kisebb, mint Csíkszereda levegőjében (1642 penész/m3), míg a többi öt vizsgált székelyföldi városban a temesvári értéknél kisebb volt a levegő átlagos penészgomba csíraszáma (253-545 penész/m3).
Az egyes mintavételi helyszíneket tekintve a temesvári vizsgálat során a két legmagasabb baktérium csíraszámot a Megyei korház környékén (10840 baktérium/m3) illetve a Badea Cârțan nagy zöldségpiac (6380 baktérium/m3) környékén mérték, mindkét helyszínt nagyon zsúfolt autós- és gyalogos forgalommal jellemezték. Ezek a baktériumszám értékek 2-4-szer nagyobbak, mint a legnagyobb székelyföldi érték (udvarhelyi Kaufland környéke). Ugyanakkor Temesváron a legtöbb penészgombát a korábban említett zöldségpiacon mutatták ki (1700 penész/m3), míg Csíkszeredában ennél közel 3-szor magasabb értékeket is mértünk (Márton Áron Főgimnázium melletti útkereszteződés illetve Törvényszék előtti körforgalom), és a kézdivásárhelyi vasútállomásnál is ennél magasabb a penészek száma.
Az egyes mintavételi helyszíneket tekintve a temesvári vizsgálat során a két legmagasabb baktérium csíraszámot a Megyei korház környékén (10840 baktérium/m3) illetve a Badea Cârțan nagy zöldségpiac (6380 baktérium/m3) környékén mérték, mindkét helyszínt nagyon zsúfolt autós- és gyalogos forgalommal jellemezték. Ezek a baktériumszám értékek 2-4-szer nagyobbak, mint a legnagyobb székelyföldi érték (udvarhelyi Kaufland környéke). Ugyanakkor Temesváron a legtöbb penészgombát a korábban említett zöldségpiacon mutatták ki (1700 penész/m3), míg Csíkszeredában ennél közel 3-szor magasabb értékeket is mértünk (Márton Áron Főgimnázium melletti útkereszteződés illetve Törvényszék előtti körforgalom), és a kézdivásárhelyi vasútállomásnál is ennél magasabb a penészek száma.
Shelton és munkatársai 2002-ben közölték egy széleskörű levegőmikrobiológiai tanulmány eredményét, amely során Amerika szerte több tíz városban vizsgálták a kültéri levegő (2409 mintavétel), illetve épületek beltéri levegőjében (9619 mintavétel) lévő gombák csíraszámát és összetételét. Az összesített eredmények alapján megállapították, hogy városi kültéri levegőben a gombák átlag csíraszáma 540 gomba/m3. Az esetek 95%-ban a csíraszám alacsonyabb volt mint 3200 gomba/m3 és a legmagasabb gombaszám 10000/m3 körül volt. A levegőben a leggyakoribb gombafajok a penészgombák voltak (Cladosporium, Penicillium és Aspergillus nemzetség tagjai).
Baktériumok számára vonatkozóan Tsai és munkatársai szintén Amerikában vizsgálták a 37 városban található 100 legnagyobb amerikai irodaépület belső és külső légterének bakteriális terheltségét. A tanulmány szerint a külső városi légtérben a baktériumok átlagos csíraszáma 179 baktérium/m3 volt, a mért maximális érték pedig 959 baktérium/m3. Szintén Amerikában Oregon államban végzett felmérés szerint a városi zónákban a levegőben előforduló baktériumok átlagos csíraszáma 715 baktérium/m3. Marseille levegőjét vizsgálva Di Giorgio és munkatársai megállapították, hogy a baktériumok átlagos csíraszáma 791 baktérium/m3, míg a gombák száma 92 gomba/m3. Isztanbulban végzett tanulmány esetében a városi levegőben átlagosan 340 baktérium/m3 volt kimutatható, a maximális érték pedig 1100 baktérium/m3. Egy 2007-es kínai tanulmány szerint a gyakran nagyon szennyezett levegőjű Peking belvárosában a baktériumok átlagos csíraszáma: 2217 baktérium/m3 volt.
A hazai és nemzetközi hasonló levegőmikrobiológiai vizsgálatokkal összehasonlítva általánosságban megállapítható, hogy a vizsgált időpontban a székelyföldi városok levegőjéből kimutatható baktériumok és penészgombák csíraszáma átlagosnak, normális értékűnek mondható. Ugyanakkor azt is hozzá kell tenni, hogy Csíkszeredában két nagy forgalmú útkereszteződésnél számottevően magasabb a penészek száma a normális értékeknél, ugyanez elmondható a székelyudvarhelyi Kaufland Áruház környéki magas baktériumszám esetében is.
Csíkszeredában a levegőből kimutatható magas mikrobaszámok az autósforgalom mellett azzal is összefüggésben lehetnek, hogy Csíkszereda és környéke a Csíki-medence egyik legalacsonyabb pontján fekszik. Itt teljesülnek legjobban a légköri hőinverziós feltételek, ami azt jelenti, hogy gyakran nagyon stabil a levegő, gyenge a légmozgás, ami a nedvesség és a szennyezőanyagok (pl. szállópor) felhalmozódásához vezet, még akkor is ha nincs jelentős szennyező forrás. A levegő stabilitásának köszönhetően nem tudnak eloszlani a szennyező anyagok, a felszín közelében maradnak. Ugyanezzel a levegő stabilitással magyarázható télen a hosszan tartó párás, ködös, hideg időszakok kialakulása is – nyilatkozta Dr. Szép Róbert, a Sapientia EMTE környezetmérnök szakának oktatója, aki légkörfizikai vizsgálatokkal is foglalkozik.
Mikrobák terjedése, túlélése a levegőben
A mikroorganizmusok nagy része a levegőben csak rövidebb ideig tud túlélni, gyakran csupán néhány másodpercig, percig. Azonban az ellenálló spórákat képező baktériumok, a spórákkal szaporodó penészgombák és sok más gomba, illetve a cisztákat képező egysejtű protozoonok ellenállóképességüknek köszönhetően hosszú ideig, akár évekig, évtizedekig is életképesek maradnak. A mikrobak túlélését nagyban befolyásolja a páratartalom, a hőmérséklet, UV- és más sugárzás, a levegő kémiai anyagokkal való szennyezettsége. A kültéri levegőben ősszel és nyáron van a legtöbb mikroorganizmus, a legkevesebb pedig hóval borított hideg téli viszonyok között. A számukat a levegőben nagyban befolyásolják a napszakos és évszakos meteorológiai változások, a növényzet, a szállópor, a légszennyezés, a mezőgazdasági-, ipari- és más emberi tevékenységek (pl. autósforgalom). A mikroorganizmusok magas száma a levegőben egészségügyi kockázatot is jelent: allergiás tüneteket válthatnak ki és terjedhetnek a levegővel főként légúti betegséget okozó baktériumok és gombák.
A mikroorganizmusok nagy része a levegőben csak rövidebb ideig tud túlélni, gyakran csupán néhány másodpercig, percig. Azonban az ellenálló spórákat képező baktériumok, a spórákkal szaporodó penészgombák és sok más gomba, illetve a cisztákat képező egysejtű protozoonok ellenállóképességüknek köszönhetően hosszú ideig, akár évekig, évtizedekig is életképesek maradnak. A mikrobak túlélését nagyban befolyásolja a páratartalom, a hőmérséklet, UV- és más sugárzás, a levegő kémiai anyagokkal való szennyezettsége. A kültéri levegőben ősszel és nyáron van a legtöbb mikroorganizmus, a legkevesebb pedig hóval borított hideg téli viszonyok között. A számukat a levegőben nagyban befolyásolják a napszakos és évszakos meteorológiai változások, a növényzet, a szállópor, a légszennyezés, a mezőgazdasági-, ipari- és más emberi tevékenységek (pl. autósforgalom). A mikroorganizmusok magas száma a levegőben egészségügyi kockázatot is jelent: allergiás tüneteket válthatnak ki és terjedhetnek a levegővel főként légúti betegséget okozó baktériumok és gombák.
Azt hogy a mikroorganizmusok mennyi ideig tartózkodnak a levegőben és mekkora távolságokat tesznek meg szintén sok tényező befolyásolja, elsősorban a légmozgás, a csapadék, a lebegő szemcsék száma és nagysága. Általában városi környezetben legfeljebb 10 perc – 1 óra időt tölt egy mikroba a levegőben, és ezen idő alatt maximum 100-1000 m távolságot tesz meg.
A mikroorganizmusok számát mikroba/m3 levegő egységben szokták megadni. Egy felnőtt ember normál körülmények között átlagban fél liter levegőt szív be belégzéskor, és percenként 12-szer vesz levegőt. Így tehát egy ember általában percenként 6 liter levegőt lélegzik be, azaz egy köbméter (1000 liter) levegőt 2 óra 46 perc alatt szívunk be, és mindez 24 órára vonatkoztatva 8,64 m3 levegőt jelent.
Csíkszereda, 2016 december 15.
Dr. Máthé István
Sapientia EMTE
Biomérnöki Tanszék
MELLÉKLET
2016. október végén – november elején hat székelyföldi városban elvégzett kültéri levegő-mikrobiológiai vizsgálat során kapott eredmények összesítő táblázatai
| CSÍKSZEREDA | |||
| Mintavételi helyszín | Baktérium/m3 | Penészgomba/m3 | Összmikroba/m3 |
| Hargita megyei törvényszék melletti körforgalom | 280 | 4587 | 4867 |
| Vasúti felüljáró előtti körforgalom (Penny Marketnél) | 2120 | 1200 | 3320 |
| Kaufland Áruház környéke | 547 | 307 | 854 |
| Márton Áron Főgimnázium melletti útkereszteződés | 333 | 4800 | 5133 |
| Központi Piac | 1600 | 1213 | 2813 |
| Vasútállomás | 960 | 413 | 1373 |
| Központi park | 147 | 387 | 534 |
| Főtér | 213 | 227 | 440 |
| Átlag érték | 775 | 1642 | 2417 |
| Minimum érték | 147 | 227 | – |
| Maximum érték | 2120 | 4800 | – |
| SZÉKELYUDVARHELY | |||
| Mintavételi helyszín | Baktérium/m3 | Penészgomba/m3 | Összmikroba/m3 |
| Református Kollégium előtti útkereszteződés | 267 | 573 | 840 |
| Buszállomás | 693 | 240 | 933 |
| Kaufland Áruház környéke | 2853 | 160 | 3013 |
| Központi Piac | 1013 | 280 | 1293 |
| Vasútállomás | 627 | 467 | 1093 |
| Szoborpark | 720 | 187 | 907 |
| Központi park | 960 | 227 | 1187 |
| Átlag érték | 1019 | 305 | 1324 |
| Minimum érték | 227 | 160 | – |
| Maximum érték | 2853 | 573 | – |
| GYERGYÓSZENTMIKLÓS | |||
| Mintavételi helyszín | Baktérium/m3 | Penészgomba/m3 | Összmikroba/m3 |
| Salamon Ernő Elméleti Líceum előtti főút | 280 | 573 | 853 |
| BRD Bankhoz közeli nagy körforgalom | 680 | 387 | 1067 |
| Buszállomás | 893 | 80 | 973 |
| Kaufland Áruház környéke | 520 | 560 | 1080 |
| Zöldséges üzletsor (Virág negyed) | 333 | 413 | 747 |
| Vasútállomás | 1267 | 80 | 1347 |
| Központi park | 93 | 53 | 147 |
| Központi Játszótér | 187 | 133 | 320 |
| Átlag érték | 532 | 285 | 817 |
| Minimum érték | 93 | 53 | – |
| Maximum érték | 1267 | 573 | – |
| TUSNÁDFÜRDŐ | |||
| Mintavételi helyszín | Baktérium/m3 | Penészgomba/m3 | Összmikroba/m3 |
| CEC Bankhoz közeli útkereszteződés | 280 | 133 | 413 |
| Tusnád Hotel előtti főút környéke | 1400 | 53 | 1453 |
| Petrom töltőállomás melletti piac környéke | 187 | 147 | 333 |
| Csukás Hotel felé vezető út mentén | 507 | 1147 | 1653 |
| Csukás-tó partja | 160 | 107 | 267 |
| Tusványos tábor bejárata | 320 | 427 | 747 |
| Vasútállomás | 13 | 160 | 173 |
| Központi játszótér | 520 | 133 | 653 |
| Átlag érték | 423 | 288 | 711 |
| Minimum érték | 13 | 53 | – |
| Maximum érték | 1400 | 1147 | – |
| SEPSISZENTGYÖRGY | |||
| Mintavételi helyszín | Baktérium/m3 | Penészgomba/m3 | Összmikroba/m3 |
| Rompetrol benzinkúthoz közeli nagy körforgalom | 1667 | 187 | 1854 |
| Buszállomás környéke | 1320 | 400 | 1720 |
| Kaufland Áruház környéke | 413 | 67 | 480 |
| Központi Piac | 1147 | 147 | 1293 |
| Vasútállomás | 160 | 227 | 387 |
| Központi Park | 747 | 547 | 1293 |
| Gödri Ferenc Általános Iskola előtti út | 602 | 201 | 803 |
| Átlag érték | 865 | 253 | 1119 |
| Minimum érték | 160 | 67 | – |
| Maximum érték | 1667 | 547 | – |

2026-01-29
Huszadik alkalommal hirdetik meg a Zöldövezet Programot

Hirdetés
repyx.com - Applikációk, webáruházak és archiváló rendszerek fejlesztése

2026-01-08
A hatóságok ajánlásokat fogalmaztak meg a rossz időre való tekintettel

Hirdetés
repyx.com - Applikációk, webáruházak és archiváló rendszerek fejlesztése

2025-12-08
